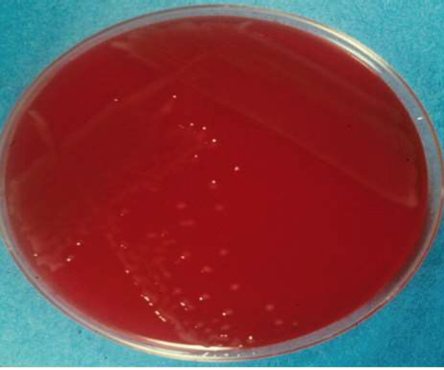

Pasteurellaceae is a gram _____ bacteria.
Negative
[rods]

Pasteurellaceae is oxidase _______.
Positive
Does Pasteurellaceae grow well on MacConkey agar?
Nope
True/False. Pasteurella spp. are falcultative anaerobes.
True.
True/False. Pasteurellaceae is an intracellular pathogen.
False. It is an extracellular pathogen.
Is Pasteurellaceae zoonotic?
Yes but Pasteurella spp. are noticeably absent from human URT flora.
Human infection with **P. multocida **usually occurs through animal bites.
(severe, rapidly progressing cellultitis may develop after deep needle-like penetrating bite like a stupid cat bite)
Which type of P. multocida causes Fowl cholera, Rabbit snuffles and bovine pneumonia?
Type A
Which type of P. multocida causes hemorrhagic septicemia?
Type B2 and E2
Which type of P. multocida causes atrophic rhinitis?
Type D
Which test do you perform to differientiate between the capsular types of Pastuerella?
Indirect hemagglutination
Which virulence factor is the basis for serogroups A-E?
The capsule
What conditions contribute to the diseases caused by Pasteurella?
Environmental stress - ex: overcrowding, etc.
What is the most important extracellular product of Pasteurella that is specifically important in atrophic rhinitis?
Pasteurella multocida toxin (PMT)
Which species does Type B and E Pasteurella cause disease in? Which disease? Which part of the world?
Fatal disease in cattle and water buffalos in the tropics
Hemorrhagic septicemia (morbidity and mortalitiy 50-100% which means it kills them really fast)
[basically the cows get a severe URI and start salivating with nasal discharge, edematous swelling in the submandibular region to neck and brisket, then respiratory distress with frothing at the mouth and they die]
[in calves, hemorrhagic gastroenteritis may occur]
Which types of Pasteurella cause fibrinous brocho and plueropneumonia and is associated with shipping fever? Which species do these types affect?
Type A and D
Bovine and porcine
[occurs as a part of bovine respiratory disease complex]
Which birds are more susceptible to fowl cholera? Mature or young?
Mature ones
Which spp of Pasteurella causes fowl cholera?
Pasteurella multocida {Type A}
What kind of disease is Fowl Cholera? Why is it historically significant?
Invasive, septicemic disease of avian hosts
{Can have high morbidity and moraltity}
Louis Pasteur demonstrated the protective efficacy of heat inactivated baterins for vaccines

Which species does Type D Pastuerella affect and what disease does it cause?
Pigs
Atrophic rhinitis

What clinical signs would expect to see in a pig affected with atrophic rhinitis?
Chronic progressive rhinitis throughout growing period with nasal turbinate atropy and varying degrees of facial deformity
Which extracellular toxin does B. bronchiseptica produce that accumulates in the bacterial cell and inhibits osetoblast differientiation, causing a regressive form of AR in young pigs?
Dermonecrotic Toxin (DNT)
[constitiutively activates Rho GTPases in target cells by covalent modification and causes cytoskeletal rearrangements]
Which species of Pasteurella causes atropic rhinitis in pigs?
Frequently associated with B. bronichiseptica and toxgenic P. multocida (type D) infection
[air quality is a determinant of disease, ex: dust)
Which extracellular pathogen produced by Pasteurella multocida accumulates in the bacterial cell and increases osteoclastic activity and reduces osetoblast activity, causing a progressive form of AR in pigs?
Pastuerella multocida Toxin (PMT)

How can you tell if your pigs have progressive AR or regressive AR?
Regressive AR will only have a DNT positive test
Progressive AR will be DNT positive and PMT positive